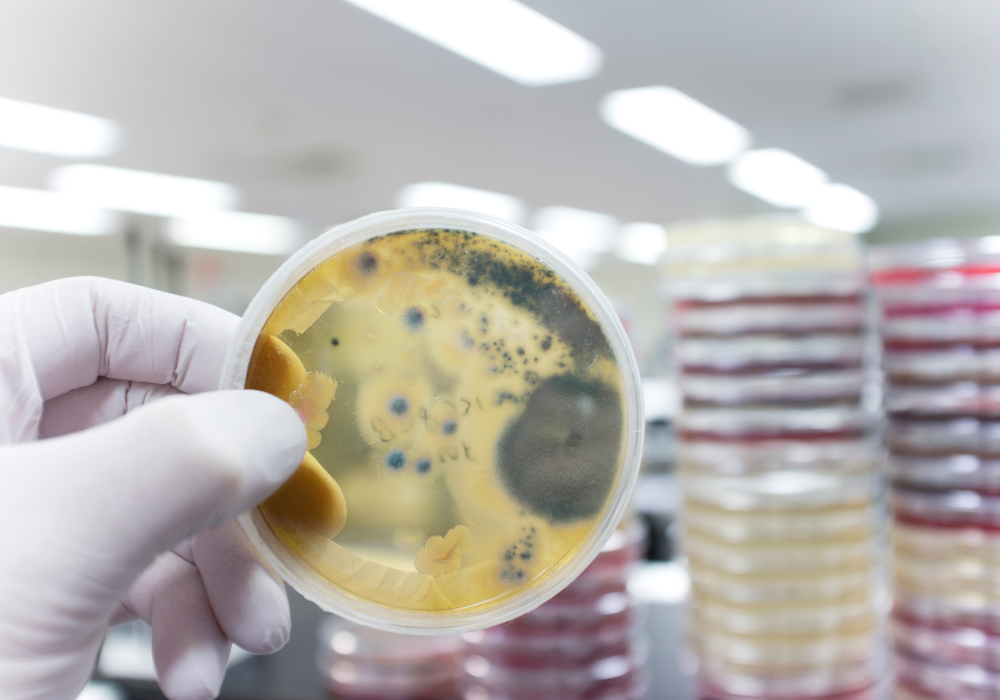

How rising temperatures may expose risks frozen for thousands of years.

Permafrost isn’t just frozen dirt; it’s a time capsule. For millennia, this icy ground has locked away ancient animals, forgotten ecosystems, and microbes from an era when humans hadn’t even mastered fire. But thanks to climate change, Arctic temperatures are rising fast, and all that buried history is starting to thaw.
The consequences are more than geological. As this frozen ground softens, it’s not just revealing mammoth bones and prehistoric forests. It’s potentially unleashing viruses and bacteria that haven’t seen a living host in tens of thousands of years. Researchers have already revived ancient microbes in lab settings, proving that survival is possible even after millennia on ice.
1. Prehistoric viruses are waking up, and our immune systems are clueless.

Frozen viruses from ancient times have been pulled from thawing permafrost, and in some cases, brought back to life. Researchers isolated a virus from 30,000-year-old permafrost samples, demonstrating its ability to infect amoebas after millennia of freezing. These aren’t dusty fossils or fragments of DNA. Some are fully intact, biologically active, and still capable of infecting cells after tens of thousands of years.
That’s alarming because our immune systems and modern medicine have never encountered anything like them. If one of these ancient viruses adapts to our environment and finds a way into human or animal hosts, it could spark an outbreak with no treatments, no vaccines, and no historical roadmap.
2. Long-dead animals are thawing out—and they might not be alone.

Woolly mammoths, ancient cave lions, and even extinct horses are emerging from the melting permafrost with some specimens remarkably preserved, including flesh and fur. These Ice Age creatures are more than fascinating relics; they’re possible carriers of ancient microbes that haven’t interacted with living systems in millennia.
In 2016, a thawed reindeer carcass released anthrax spores that infected dozens of people and killed a child in Siberia. As more of these carcasses emerge from the melt, so do the invisible passengers that may be waiting inside.
3. Bacteria with ancient grudges are slipping back into the world.

Bacteria don’t need to roar back with drama to be dangerous—they just need to survive long enough to spread. Scientists have discovered viable strains of bacteria in thawing permafrost, some of which carry ancient antibiotic-resistance genes. These microbes have been frozen for thousands of years, developing in total isolation from modern medicine and immune systems.
Once reactivated, they can seep into waterways, soil, or animal populations. Some may interact with contemporary bacteria, swapping resistance genes and giving rise to hybrid superbugs. These kinds of evolutionary jumps are silent but incredibly potent. If they enter the food chain or water systems unnoticed, they could spark outbreaks that are difficult to track, diagnose, or treat.
4. Buried epidemic graves may be thawing with something still inside.

In remote parts of Alaska and Siberia, scientists have located burial pits from historic epidemics such as smallpox, the Spanish flu, and other unidentified diseases. These graves were once sealed in permafrost, preserving not just the victims but the viruses that may have helped kill them.
Fragments of smallpox DNA have already been recovered from old remains, and while they weren’t infectious, they raise major concerns. Melting ground can disturb these sites naturally or through construction projects, risking the release of forgotten killers back into circulation. The past isn’t staying buried; it’s rising with the temperature.
5. Ancient fungi could sneak in under the radar.
Viruses and bacteria tend to dominate the spotlight when it comes to infectious threats, but fungi are the stealthy intruders of the microbial world. Their spores are remarkably resilient, capable of surviving in extreme cold for thousands of years. As global temperatures rise and permafrost begins to thaw, these long-dormant spores can be released into the environment, drifting into the air or seeping into water supplies.
Unlike many viral or bacterial infections, fungal infections often progress silently, going undetected until they’ve already taken hold. What makes fungi especially dangerous is their ability to adapt quickly to changing environments. Warmer climates are now creating ideal conditions for ancient or previously dormant fungal species to thrive.
6. Microbial chaos is spreading through Arctic soil like wildfire.

The microbes that naturally exist in permafrost are ancient but essential. They help manage soil health, process nutrients, and keep ecosystems in balance. But thawing ground is flipping that balance on its head. Some microbes are vanishing, while others are multiplying faster than ecosystems can handle.
When the microbial community shifts, the whole Arctic food web can get thrown out of whack. New microbes may dominate, soil nutrients could deplete or over-accumulate, and native plants might lose the support systems they’ve evolved to depend on. From the tiniest fungi to the biggest caribou, the ripple effects could be massive.
7. Methane-spewing craters are exploding out of the Arctic tundra.

One of the eeriest side effects of thawing permafrost is the sudden appearance of massive craters in places like Siberia. They’re the result of methane gas explosions. As organic matter thaws and decomposes, it releases methane, a powerful greenhouse gas that builds up until the pressure literally blows a hole in the ground.
More importantly, they’re a troubling sign that climate change is now feeding itself. Methane is more than 25 times more potent than carbon dioxide at trapping heat, meaning each explosion makes the planet warm even faster, melting more ground and restarting the cycle all over again.
8. Reawakened microbes could leap from wild animals into humans.

Zoonotic diseases, those that jump from animals to humans, have already made headlines around the world, and permafrost melt could increase the odds of that happening again. As ancient microbes reemerge, they could infect Arctic wildlife, which may act as new hosts or carriers.
With more human activity in the Arctic, including mining, oil exploration, and tourism, the chances of human-wildlife contact are growing. If an old virus adapts to a modern animal and mutates just enough, it could cross into people, just like other zoonotic viruses have. It wouldn’t be the first time humanity got blindsided by something microscopic.
9. Melting permafrost could reactivate ancient plant pathogens.

It’s not just humans and animals that are at risk. Thawing soil can also unearth plant pathogens like fungi, viruses, or bacteria that once infected prehistoric vegetation. If even a fraction of these ancient agricultural threats regain their strength, they could wreak havoc on today’s crops, which have never evolved defenses against them.
This could affect everything from wild forest systems to global food supplies. Our current agricultural infrastructure is already fragile in the face of climate stress, and a wave of unknown diseases targeting plants could send food security into a tailspin. We tend to think of disease in human terms, but ecosystems rely on healthy plants just as much as we do.
10. Thawed toxins could seep into water supplies and poison communities.

Permafrost holds decades’ worth of toxic chemicals, including mercury, arsenic, and pollutants from Cold War-era military bases. As that frozen ground breaks down, these substances can leach into nearby lakes, rivers, and groundwater supplies, putting entire communities at serious risk, especially Indigenous and rural Arctic populations.
Once these toxins enter the water, they’re nearly impossible to remove. Mercury contamination, in particular, is a long-term threat that can affect brain development and reproductive health. With the Arctic warming faster than any other region on Earth, the window for prevention is closing quickly.
11. The Arctic carbon bomb could accelerate climate change worldwide.

Permafrost contains an estimated 1.5 trillion tons of carbon, more than double what’s currently in the atmosphere. When it melts, that organic matter decomposes, releasing carbon dioxide and methane into the air.
Scientists call this the “Arctic carbon bomb” because once it’s triggered, it could speed up global warming dramatically. Once the thaw starts, there’s no way to stop it. It’s a feedback loop: warming melts permafrost, which releases greenhouse gases, which causes more warming.
12. Ecosystems that once thrived in cold stability are being thrown into chaos.

The Arctic used to be one of the planet’s most stable regions, as it was frozen, predictable, and slow to change. But now, entire ecosystems are unraveling. Animal migration routes are shifting. Insects are moving north. Trees are growing in what used to be tundra. It’s not just thawing; it’s ecological whiplash.
Permafrost provided a foundation for everything that lived above it. As it destabilizes, so do the plants and animals that depend on its consistency. The more the ground melts, the harder it becomes for life in the Arctic to adapt.
